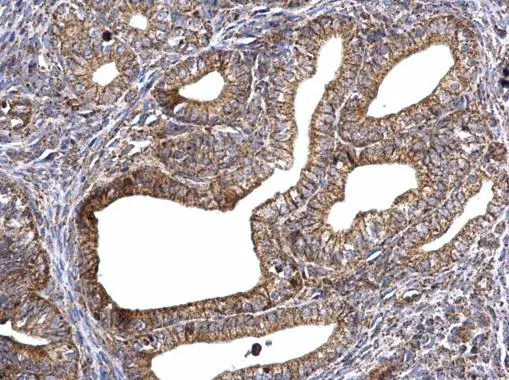
ATP synthase gamma antibody detects ATP synthase gamma protein at mitochondria on mouse cervix by immunohistochemical analysis. Sample: Paraffin-embedded mouse cervix. ATP synthase gamma antibody (GTX114275) dilution: 1:500. 
 Antigen Retrieval: Trilogy? (EDTA based, pH 8.0) buffer, 15min

ATP synthase gamma antibody detects ATP5C1 protein by western blot analysis. A. 50 μg rat kidney lysate/extract 12% SDS-PAGE ATP synthase gamma antibody (GTX114275) dilution: 1:5000 The HRP-conjugated anti-rabbit IgG antibody (GTX213110-01) was used to detect the primary antibody.
ATP synthase gamma antibody
GTX114275
ApplicationsImmunoPrecipitation, Western Blot, ImmunoHistoChemistry, ImmunoHistoChemistry Paraffin
Product group Antibodies
ReactivityHuman, Mouse, Rat, Zebra Fish
TargetATP5F1C
Overview
- SupplierGeneTex
- Product NameATP synthase gamma antibody
- Delivery Days Customer9
- Application Supplier NoteWB: 1:1000-1:10000. IHC-P: 1:100-1:1000. *Optimal dilutions/concentrations should be determined by the researcher.Not tested in other applications.
- ApplicationsImmunoPrecipitation, Western Blot, ImmunoHistoChemistry, ImmunoHistoChemistry Paraffin
- CertificationResearch Use Only
- ClonalityPolyclonal
- Concentration0.55 mg/ml
- ConjugateUnconjugated
- Gene ID509
- Target nameATP5F1C
- Target descriptionATP synthase F1 subunit gamma
- Target synonymsATP5C, ATP5C1, ATP5CL1, ATP synthase F(1) complex subunit gamma, mitochondrial, ATP synthase gamma chain, mitochondrial, ATP synthase subunit gamma, mitochondrial, ATP synthase, H+ transporting, mitochondrial F1 complex, gamma polypeptide 1, F-ATPase gamma subunit, mitochondrial ATP synthase, gamma subunit 1
- HostRabbit
- IsotypeIgG
- Protein IDP36542
- Protein NameATP synthase F(1) complex subunit gamma, mitochondrial
- Scientific DescriptionThis gene encodes a subunit of mitochondrial ATP synthase. Mitochondrial ATP synthase catalyzes ATP synthesis, utilizing an electrochemical gradient of protons across the inner membrane during oxidative phosphorylation. ATP synthase is composed of two linked multi-subunit complexes: the soluble catalytic core, F1, and the membrane-spanning component, Fo, comprising the proton channel. The catalytic portion of mitochondrial ATP synthase consists of 5 different subunits (alpha, beta, gamma, delta, and epsilon) assembled with a stoichiometry of 3 alpha, 3 beta, and a single representative of the other 3. The proton channel consists of three main subunits (a, b, c). This gene encodes the gamma subunit of the catalytic core. Alternatively spliced transcript variants encoding different isoforms have been identified. This gene also has a pseudogene on chromosome 14. [provided by RefSeq]
- ReactivityHuman, Mouse, Rat, Zebra Fish
- Storage Instruction-20°C or -80°C,2°C to 8°C
- UNSPSC41116161